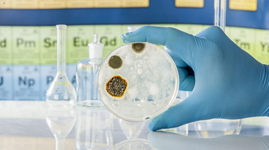
Testing for mould in a lab

SAN-AIR™ Mould Removal & Prevention Categories
SAN-AIR™ Mould Removal & Prevention
-


SAN-AIR™ Surface Mould Remover
High-penetration mould spray for effective microbe control SAN-AIR™ Surface Mould Remover is a ready-to-use solution designed for effective mould, bacteria, and germ elimination. No dilution is required, making it convenient and easy to apply directly from the bottle. It is formulated with isopropyl for better penetration and faster drying for efficient cleaning and sanitisation. SAN-AIR™ Surface Mould Remover doesn't just stop at removing mould – it neutralises toxic mould and mildew, eliminates bacteria, and banishes unpleasant odours. By reducing your mould cleaning frequency, it streamlines your cleaning routine, saving you time and effort! Key benefits of using the SAN-AIR™ Surface Mould Remover spray: Effectively disinfects surfaces with mould Kills 99.9% mould, germs and bacteria Protects cleaned surface for up to 12 months Removes odour 100% natural active ingredients Environmentally friendly with non-toxic and non-corrosive formulation 100% biodegradable and sustainable Fast acting Does not damage surfaces Laboratory tested and validated Pet and plant friendly Food safe certified Made in Australia Applications Any surfaces including shower stalls, glasses, walls, ceilings and furniture etc. Air conditioning units Refill the SAN-AIR Surface Mould Remover into smaller spray bottles or the SAN-AIR Atomiser using the silicone collapsable funnel. Download Product Data Sheet Download Safety Data Sheet Buy this item in a bundle and receive 10% here
$21.94 - $260.97
-


SAN-AIR™ LD Concentrate - Natural Mould Cleaner & Sanitiser
Natural Multi-Purpose Cleaning Concentrate NOTE: Product needs to be diluted before use (Please follow instructions for use) The SAN-AIR™ LD Concentrate is a powerful, multi-purpose cleaner and mould remover made from 100% natural, non-toxic ingredients. This water-based cleaning concentrate is designed for both general surface cleaning and targeted microbial contamination treatment—including mould, bacteria, and flood-related odours. When diluted at either a 20:1 or 50:1 ratio (depending on the task), this fast-acting cleaning liquid delivers exceptional results across a wide range of surfaces and applications. Whether you're refreshing soft furnishings, cleaning appliances, or tackling stubborn mould on walls or fabrics, SAN-AIR LD Concentrate works like the best cleaning agent—tough on germs, gentle on your environment. Unlike harsh chemical cleaners, it contains no isopropyl alcohol (IPA) and is safe for use around children, pets, and even plants. Lightly scented with essential oils, it leaves your space clean, fresh, and free from harmful residues. Where to Use It: Laundry – Add diluted solution to your washing machine to eliminate odours and mould from fabrics. Dishwashers – Run through the rinse cycle to sanitise and deodorise your dishwasher. Surfaces – Suitable for walls, ceilings, plastic, timber, canvas, leather, vinyl, tiles, laminate, chrome, glass, limestone, marble, porcelain, and more. Mould remediation & flood restoration – Ideal for serious microbial contamination, such as damp or water-damaged areas. Key features: For surface cleaning, mould removal & mould inhibiting Safe to breathe & touch Effectively kills 99.9% of bacteria, germs & mould Long lasting & cost effective Fast acting formulation Non-allergenic Made from 100% natural ingredients Food-safe certified Toxic chemical-free Biodegradable & sustainable Independently tested & validated Pregnant women, children, pet & plant-friendly Complies with ASNZ 3666.4 Note: You can refill the LD Concentrate into smaller spray bottles or the SAN-AIR Atomiser using the silicone collapsable funnel.
$44.95 - $447.75
-


SAN-AIR™ Mould Gone Reactive Gel
SAN-AIR™ Mould Gone – Natural Mould Control That Works Say goodbye to unwanted mould, bacteria, and spores with SAN-AIR™ Mould Gone – a powerful, plant-based mould removal gel designed for enclosed, humid spaces. Whether you’re dealing with persistent odours or looking to prevent future mould outbreaks, this gel mould remover offers a simple, mess-free solution that purifies your air and protects your space. Formulated with non-toxic, plant-derived actives, SAN-AIR™ Mould Gone diffuser gel kills 99.99% of airborne bacteria, mould, and spores. The water-based gel slowly evaporates into the air, spreading throughout your indoor environment. As it comes into contact with microbes on surfaces and in the air, it stops mould from accessing oxygen and halts bacteria from reproducing—effectively neutralising their ability to grow. Perfect for use as mould treatment in high-humidity areas such as: Home - Bedrooms, bathrooms, kitchens, garages, closets and garages Commercial facilities- Office spaces, meeting rooms, storage areas, retail spaces, stockrooms, changing rooms, classrooms, and play areas Industrial facilities - Warehouses, hospitals, clinics, laboratories, manufacturing facilities Air conditioning systems & air handlers Features & Benefits: Ideal for residential, commercial and industrial environments Fast acting Easy to use Environmentally friendly with non-toxic & non-corrosive formulation Made from natural ingredients Laboratory tested & validated Pet and plant-friendly 24/7 protection for up to 3 months Long-lasting effects Cost-effective - no professional mould cleaning needed Food safe certified Made in Australia Broad spectrum efficacy - species used: Micrococcus Luteus Staphylococcus Capitis Staphylococcus Hominis Escherichia Coli Staphylococcus Aureas Pseudomonas Aeruginosa Aspergillus Niger (Mould) Listeria Monocytogenes Did You Know? You can pair SAN-AIR™ Mould Gone with a diffuser to help distribute the gel more evenly throughout your space for mould removal and mould treatment. It’s a great way to boost coverage in larger or poorly ventilated areas. 👉 Watch our video guide to learn how it’s done. For more tips, check out our blog articles on mould removal and mould prevention right HERE! Buy this item in a bundle and receive 10% here
$27.44 - $302.94
-


SAN-AIR™ V3R Commercial/Household Grade Disinfectant
Your all-in-one solution for a clean and germ-free environment Need a household or commercial-grade disinfection? The SAN-AIR™ V3R Surface Disinfectant is specifically formulated to target mould, germs, bacteria, and is proven effective against COVID-19, ensuring comprehensive protection for your space. Experience the peace of mind that comes with using a disinfectant made from 100% natural actives and free from harsh chemicals. SAN-AIR™ V3R disinfectant is a versatile solution suitable for both soft and hard surfaces. Refill the V3R Commercial Household Grade Disinfectant into smaller spray bottles or the SAN-AIR Atomiser using the silicone collapsable funnel. Key benefits of using the SAN-AIR™ V3R Disinfectant Effectively disinfects surfaces Targets mould, bacteria, germs, and effective against COVID-19 Ideal for residential and commercial environments Fast acting Non allergenic Environmentally friendly with non-toxic and non-corrosive formulation Made from natural ingredients 100% biodegradable and sustainable Does not damage surfaces Laboratory tested and validated Pet and plant friendly Food safe certified Made in Australia Applications Any surfaces including door knobs, walls, ceilings and furniture etc. Air conditioning units Kitchen countertops and appliances Download Product Data Sheet Download Safety Data Sheet
$37.95 - $365.00
-

SAN-AIR™ V3R Split System Reactive Gel - 10 Pack
Keeps your air conditioner mould-free Kills 99% of mould, bacteria, germs, fungus, and spores The SAN-AIR™ V3R Split System Reactive Gel is a specially designed air conditioning cleaner to combat mould growth in any air conditioning units. Compact and powerful, this gel is engineered to fit seamlessly into any Split System air conditioner, providing complete mould cleaning and maintenance. By reducing dirty, stale, and musty air, it not only enhances your air quality but also prolongs the life of your unit. The advanced formula not only removes existing mould but also prevents its return, guaranteeing a continuous supply of clean and healthy air in your space. Key benefits Ideal for residential, commercial & industrial environments Fast acting Easy to use Environmentally friendly with non-toxic & non-corrosive formulation Made from natural ingredients Laboratory tested & validated Pet and plant-friendly Lasts 8-12 weeks* Cost-effective - no professional mould cleaning needed Food safe certified Made in Australia * Depends on temperature, humidity and frequency of air-conditioner use. Download Product Data Sheet Download Safety Data Sheet
$181.50 $179.65
-


SAN-AIR™ V3R Air Conditioning & Air Handler Gel Diffusers
24/7 Mould & Bacteria Control for Air Conditioning Systems Made in Australia Designed for both residential and commercial use, these innovative mould removal products improve indoor air quality 24/7, ensuring your spaces are healthier, safer, and free from harmful contaminants. Whether you're looking for a natural mould remover or a reliable gel mould remover, SAN-AIR™ provides an effective and chemical-free solution to maintain your air conditioner unit. How It Works The SAN-AIR™ V3R Gel Diffusers use a water-based gel that evaporates into the air, spreading throughout your indoor environment. As it disperses, the gel actively targets and eliminates airborne microbes, stopping bacteria from reproducing and depriving mould of oxygen. This advanced process not only kills 99.99% of airborne bacteria, mould, and spores but also prevents their growth and reproduction on surfaces. Key Features: Made from 100% natural actives 24/7 protection Kills 99.99% of airborne bacteria, mould & spores Eliminates nasty, musty, unpleasant odours Certified food safe Laboratory tested and validated Easy to use & fast-acting Long-lasting & cost-effective No harsh chemicals Non-toxic formulation Non-allergenic Biodegradable & sustainable Children, pet & plant-friendly Why Choose SAN-AIR™ V3R Gel Diffusers? SAN-AIR™ is a trusted name in mould removal products, offering advanced, all-natural solutions for cleaner air and safer environments. With a focus on safety and sustainability, this natural mould remover not only cleans but also prevents recurring problems, making it a must-have for homes and businesses alike. Applications: The SAN-AIR™ V3R Air Conditioning & Air Handler Gel Diffusers are each tailored to specific uses: 1. V3R Air Handler Reactive Gel Ideal for large and small ducted air conditioning systems. Suitable for use in commercial and residential spaces. Perfect for large storage areas, basements, and any other enclosed spaces needing mould control products. 2. V3R Air Conditioning Reactive Gel Designed for use in air conditioning systems and air handlers. Effective in enclosed spaces such as homes, workplaces, and other indoor environments. Lasts up to 10 weeks when used according to the recommended size for your area: SAN-AIR™ V3R Air Handler/Air Conditioning Gel Diffuser Size For Area Size 100g Air Conditioning Gel Diffuser Up to 150m² 250g Air Handler Gel Diffuser Up to 375m² 500g Air Handler Gel Diffuser Up to 750m² 1kg Air Handler Gel Diffuser Up to 1500m²
$36.00 - $272.94
-


Sleek Air Diffuser
Experience superior air quality with advanced diffusion technology Designed exclusively for use with the SAN-AIR™ Reactive Gel jars, the Sleek Air Diffuser is the perfect complement to SAN-AIR™ air purification products, ensuring your space is always fresh and clean. The Sleek Air Diffuser operates seamlessly, distributing the reactive gel into the air and throughout the room, effectively reaching even the most challenging, hard-to-reach areas. Its compact and durable design makes it a reliable addition to any room, offering both freestanding and wall-mountable options for your convenience. Customise your air purification experience with the diffuser's versatile features. With three handy interval settings and options for 24-hour, night, or day use, you have the flexibility to tailor the diffuser to your specific needs. Features and benefits of the air diffuser: Ideal for use in any room that does not have steady airflow Sleek and durable design in either Grey or Blue Can be used freestanding or wall mountable Requires 2x AA batteries - purchase the Energizer AA Batteries here Can be used with SAN-AIR Reactive Gel jars and mozzie repellent: SAN-AIR™ Mould Gone SAN-AIR™ V3R Air Purifier Reactive Gel SAN-AIR™ Caravan, Boat & Storage Reactive Gel SAN-AIR™ Mozzyno Mosquito Repellent *Important note: The Sleek Diffuser does not include SAN-AIR™ Reactive Gel jars and Mozzyno Mosquito Repellent. The items are sold separately. If you want to purchase the Reactive Gel products, click here. 2x A4 Batteries are required (not included with the Air Diffuser) Buy this item in a bundle and receive 10% here
$59.00 $46.50
-


Fan Fresh Wall Mounted Diffuser / Dispenser - Professional Edition
Upgrade your air care experience Please note: This diffuser model comes without an LED light indicator. Rest assured, all other features remain the same, and it still operates efficiently using batteries. The Fan Fresh Diffuser includes a 1-year warranty for eligible faults or issues. The Fan Fresh Wall Mounted Diffuser/Dispenser is a professional-grade air freshener dispenser designed to enhance airflow and efficiently spread fragrance throughout your space. The fragrance dispenser features a unique fan design that promotes optimal airflow, ensuring the chosen fragrance spreads efficiently throughout your space. Programmed settings allow you to fine-tune the fragrance distribution for maximum impact. Designed for easy wall mounting, this wall air freshener ensures the dispenser is securely placed for optimal performance and fragrance distribution. Key features: Optimises airflow through programmed settings Interchangeable motor for easy maintenance Offers 24H, Night, and Day modes Three working modes accommodates various types of refills and vaporisation requirements Dual power supply using D-size alkaline battery or DC power 3V/1A. Not included Openings on all four sides ensure efficient airflow Made primarily of environmentally friendly polypropylene, resistant to fragrance Security key and lock for added safety Additionally, the fragrance dispenser accommodates a variety of refills: Universal refills - Compatible with various commercially available refills. 80ml refillable bottle with wick - Use your preferred essential oils or fragrances for a personalised touch. Ideal to use in: Offices Hotels Restaurants Public restrooms Homes And many more! Buy this item in a bundle and save 10% here Power Source: Batteries sold separately here OR DC 3V/1A Power Adapter sold separately here Fan Fresh Diffuser Power Source
$58.95
-

Portable Nano Atomiser
Compact Fogger Spray for Powerful Sanitisation The Portable Atomiser is a lightweight, handheld fogger spray that delivers advanced disinfection and odour control in homes, offices, classrooms, and commercial spaces. Designed to work seamlessly with SAN-AIR™ V3R Disinfectant and Mould Removal solutions, this compact device transforms liquid into an ultra-fine mist, evenly coating surfaces with sanitising power. Whether you're targeting everyday germs or tackling persistent mould, this versatile atomiser offers a highly effective solution. When paired with SAN-AIR’s mould treatment products, it functions as a reliable mould fogger, helping eliminate airborne spores and prevent regrowth. Its nano atomisation technology ensures thorough coverage without leaving residue, making it perfect for high-touch surfaces, soft furnishings, and hard-to-reach areas. With simple controls and a portable design, the Atomizer makes professional-grade cleaning accessible for anyone. Key features: Advanced sanitisation and disinfection Excels at removing persistent odours Easy operation for convenience Perfect for various settings (schools, home, office) High fog coverage *Important note: The Portable Nano Atomiser does not include SAN-AIR™ V3R Commercial/Household Grade Disinfectant. The items are sold separately. If you want to make a purchase of the disinfectant product, click here. Buy this item in a bundle and receive 10% here
$85.73 $60.44
-


Energizer Max Plus AA Alkaline Batteries
Power up your devices with Energizer Max Plus AA Batteries, the ultimate solution for long-lasting energy and offer an extended shelf life of 12 years. These long lasting AA batteries deliver reliable performance and extended runtime to ensure your high drain devices stay powered. The enhanced leak resistance batteries safeguard your devices and surroundings against potential damage from leaks. The Energizer high-performance AA batteries are suitable for a range of electronic devices, toys, remotes, home appliances, consoles and more. Compatible to use with the SAN-AIR diffuser.
$14.95 - $21.95
-


SAN-AIR™ Mould Treatment Starter Pack
Your complete mould removal solution for a mould-free environment Please note: The White Air Diffuser in the bundle variant comes without a flashing LED indicator light so it will not disturb you during the night. This does not impact performance — it still operates exactly as intended using batteries. Are you currently grappling with mould issues in your living space? Mould isn't just unsightly - it can pose serious health risks, triggering allergies, respiratory problems, and even asthma. That's why tackling mould head-on is crucial for a healthy and comfortable home. The SAN-AIR Mould Treatment Bundle is all you need in the fight against mould. This powerful trio combines the best of both worlds, offering instant solutions to mould treatment and prevention. The bundle includes: 1x SAN-AIR™ Mould Gone 1x SAN-AIR™ Surface Mould Remover 1x (option of Blue / Grey / White Air Diffuser) NOTE: The diffusers in this bundle require power to operate. Batteries and power adapters are not included in the bundles. Blue/Grey Air Diffusers require 2x AA Batteries. White Air Diffusers require D-size alkaline batteries OR a 3V/1A DC power adapter. IMPORTANT! The 3V/1A DC power adapter is only compatible with the white fan diffuser and will not work with the blue or grey models. Use the SAN-AIR Mould Treatment Starter Pack to swiftly eradicate visible mould from surfaces. But it not only removes mould but also acts as a preventive measure, hindering mould growth for a significant period of 6-8 weeks. Don’t stop there! For a more robust protection, use it together with the SAN-AIR™ Mould Gone. This water-based solution offers extended protection by inhibiting bacteria reproduction and disrupting mould growth by depriving it of essential oxygen, ensuring your space remains mould-free for up to 3 months. To maximise the effectiveness of the mould gel, pair it with SAN-AIR™ Air Diffuser. The air diffuser helps distribute the reactive gel into the air, ensuring thorough coverage throughout the room, even reaching challenging or hard-to-access areas. This combination guarantees no corner is left untreated, providing you with complete peace of mind. The natural choice for a healthy home Both the SAN-AIR Mould Remover Spray and Mould Gone gel are formulated with 100% natural ingredients that effectively kills 99% mould, bacteria and fungus. No harsh chemicals, no harmful fumes!
$94.10 - $107.08
-


SAN-AIR™ Mould Removal Bundle
Get long-lasting protection against mould Please note: The White Air Diffuser in the bundle variant comes without a flashing LED indicator light so it will not disturb you during the night. This does not impact performance — it still operates exactly as intended using batteries. The bundle includes: 1x SAN-AIR™ Mould Gone Gel 1x (option of Blue / Grey / White Air Diffuser) NOTE: The diffusers in this bundle require power to operate. Batteries and power adapters are not included in the bundles. Blue/Grey Air Diffusers require 2x AA Batteries. White Air Diffusers require D-size alkaline batteries OR a 3V/1A DC power adapter. IMPORTANT! The 3V/1A DC power adapter is only compatible with the white fan diffuser and will not work with the blue or grey models. The mould removal gel is made from 100% natural actives that are powerful enough to eliminate 99% of airborne bacteria, mould, fungus, and spores but still safe for use around kids, pets, pregnant women, and plants, providing peace of mind for your entire family. With the SAN-AIR™ Mould Removal Bundle, you can prevent mould regrowth for up to 3 months. This means that you won't have to spend time frequently cleaning and reapplying mould removal products, saving you valuable time and effort in the long run! Watch how to use the diffuser with SAN-AIR reactive gels HERE
$64.95 - $74.95
-

SAN-AIR™ Nano Bundle
Clean with complete confidence and convenience Mould removal isn't just about cleanliness; it's about safeguarding your health and wellbeing. That’s where our SAN-AIR™ Nano Bundle comes in handy! Made with 100% natural ingredients, these SAN-AIR™ products feature a non-toxic and non-corrosive formulation, ensuring safety for you and your environment. The bundle includes: 1x SAN-AIR™ Surface Mould Remover 1x SAN-AIR™ Portable Nano Atomizer 1x 10 Pack of AMD P2 Nanotech Face Masks Earloop - EP26 Med-Large White The SAN-AIR™ Surface Mould Remover Spray works effectively in eliminating 99.9% of germs, bacteria, and mould for thorough cleaning and disinfection. Mould can often lurk in those hard-to-reach crevices, making thorough cleaning a challenge. For hard-to-reach areas like these, the SAN-AIR™ Nano Atomizer provides a convenient solution. Simply pour the solution into the atomiser and spray on desired surfaces for targeted cleaning. Using the atomiser not only ensures precise application but also helps save on product with minimal wastage. Mask up to protect yourself when cleaning mould During mould cleaning, it's crucial to prioritise safety, especially when dealing with airborne mould spores. Our AMD face mask, included in the bundle, is specially designed with nanofibre technology to filter out 99.66% of airborne particles, including mould spores. Its three-panelled design and high-quality material ensure a comfortable fit, even during extended use!
$119.85 $116.00
-


SAN-AIR™ Complete Home Mould-Busting Bundle
The natural choice for lasting protection against mould Please note: The White Air Diffuser in the bundle variant comes without a flashing LED indicator light so it will not disturb you during the night. This does not impact performance — it still operates exactly as intended using batteries. Protect your home and loved ones from the dangers of mould with our SAN-AIR Complete Home Mould-Busting Bundle! Mould growth in the home can pose serious health risks, especially to respiratory health when exposed long term. With our bundle, you can eradicate mould at its source and safeguard your family's well-being. The Blue Diffuser Bundle includes: 4x Blue Sleek Air Diffuser 4x SAN-AIR™ Mould Gone Gel 1x SAN-AIR™ 500ml Mould Remover Surface Spray 1x 12 Pack of Batteries The Grey Diffuser Bundle includes: 4x Grey Sleek Air Diffuser 4x SAN-AIR™ Mould Gone Gel 1x SAN-AIR™ 500ml Mould Remover Surface Spray 1x 12 Pack of Batteries The White Diffuser Bundle includes: 4x White Air Diffuser 4x SAN-AIR™ Mould Gone Gel 1x SAN-AIR™ 500ml Mould Remover Surface Spray NOTE: The white air diffusers in this bundle require power to operate. Batteries and power adapters are not included. Require D-size alkaline batteries OR a 3V/1A DC power adapter, sold separately. To purchase, please click on these links: D-size alkaline batteries 3V/1A DC power adapter IMPORTANT! The 3V/1A DC power adapter is only compatible with the white fan diffuser and will not work with the blue or grey models. Unlike harsh chemical solutions, SAN-AIR products utilise 100% natural actives to effectively remove mould at the source and prevent its return.This powerful, yet gentle formula is safe to use around children, pets, and even plants, making it the perfect choice for creating a healthy and mould-free home environment. Watch how to use the diffuser with SAN-AIR reactive gels HERE
$301.96 - $318.30
-


SAN-AIR Mega Mould Removal Bundle
Safe and natural formula for fresher air and mould-free living Please note: The White Air Diffuser in the bundle variant comes without a flashing LED indicator light so it will not disturb you during the night. This does not impact performance — it still operates exactly as intended using batteries. Combat mould and freshen your entire home with the SAN-AIR Home Air Purification and Mould Removal Bundle! This comprehensive solution is ideal for bigger spaces or homes with many rooms. The SAN-AIR Mould Gone Gels, surface spray and air purifier gels are formulated with potent natural actives that target mould and odours at their source. To maximise their reach and ensure complete protection throughout your home, the bundle includes SAN-AIR Diffusers that works to disperse the concentrated gel formulas gently and effectively. The Blue Diffuser bundle includes: 6x SAN-AIR™ Mould Gone Gel 6x Blue Sleek Air Diffusers 1x Pack of 12 Batteries 2x SAN-AIR™ 500ml Mould Remover Surface Spray The White Diffusers bundle includes: 6x SAN-AIR™ Mould Gone Gel 6x White Fan Fresh Air Diffusers 2x SAN-AIR™ 500ml Mould Remover Surface Spray NOTE: The white air diffusers in this bundle require power to operate. Batteries and power adapters are not included. Require D-size alkaline batteries OR a 3V/1A DC power adapter, sold separately. To purchase, please click on these links: D-size alkaline batteries 3V/1A DC power adapter The White Diffuser comes with a 1-year warranty for added peace of mind. IMPORTANT! The 3V/1A DC power adapter is only compatible with the white fan diffuser and will not work with the blue or grey models. The Grey Diffusers bundle includes: 6x SAN-AIR™ Mould Gone Gel 6x Grey Sleek Air Diffusers 1x Pack of 12 Batteries 2x SAN-AIR™ 500ml Mould Remover Surface Spray We recommend placing 1x Air Diffuser and 1x Mould Gone Gel in each room that has signs of mould growth. Follow and spray affected areas with the SAN-AIR Mould Removal Spray. Follow instructions as directed. Watch how to use the diffuser with SAN-AIR reactive gels HERE
$454.18 - $469.34
-


AMD P2 Respirator Australian Made 4-Layer Nano-Tech Face Mask - Earloops
High-Performance Australian-Made P2 Respirator Mask Looking for a premium, breathable alternative to standard P2 or N95 masks? The AMD P2 Nano-Tech Respirator Mask offers advanced protection with the comfort you need for daily wear. Made in Australia, this P2 respirator mask features cutting-edge nanofiber technology that delivers high-level filtration without compromising breathability. With 99.66% Particle Filtration Efficiency (PFE) and 99.92% Bacterial Filtration Efficiency (BFE), AMD masks offer trusted protection from airborne particles, including viruses, bacteria, and dust—comparable to an N95 mask in Australia. Unlike traditional masks, AMD face masks are ultra-light, moisture-resistant, latex-free, and odour-free. Whether you're wearing it at work, on public transport, or in healthcare settings, the innovative nano-filter maintains its performance—even in humid conditions. Each P2 face mask is individually wrapped for hygiene and convenience, making it ideal for both professional and personal use. Available in White & Black Why Choose AMD P2 Face Masks? Certified protection with Level 3 fluid resistance Nano-fibers breathable design Australian-made quality Comfortable & secure fit Moisture-resistant Latex-free & odour-free Individually packed for hygiene Medical Device Class 1 ARTG listed 335981 Suitable for workplace safety & personal protection Available in colours: White Black Download Specification Sheet
$29.95 - $94.95
-


AMD P2 Respirator Australian Made 4-Layer Nano-Tech Face Mask (N4) - Headbands
Australian-Made P2 Respirator Mask with Headband – Advanced 4-Layer Filtration Need help choosing the right size? Check out our sizing guide here or try a sample pack to find your perfect fit. Engineered for dependable, high-level protection, the AMD P2 Nano-Tech Mask (N4 Headband) is an Australian-made P2 face mask built with nano-fibre filter technology to deliver outstanding breathability without compromising on safety —performance equivalent to top-tier N95 masks in Australia. Its headband design provides a secure, pressure-balanced fit that reduces discomfort over long periods—especially around the ears and temples. The 4-layer filtration system actively blocks airborne particles, viruses, smoke, dust, and other pollutants, while remaining lightweight and breathable. Made without latex and resistant to moisture buildup, this P2 respirator stays effective even in humid conditions. With minimal pressure points, it's ideal for sensitive skin and long shifts. Available in three sizes (S, M, L) to ensure the best possible seal for your face shape. Key features of AMD masks: Latex-free headband strap Compliant with AS/NZS 1716:2012 standards 99.66% Particle Filtration Efficiency (PFE) 99.92% Bacterial Filtration Efficiency (BFE) - AS 4381 Level 3 certified No nose foam 4-ply, flat-fold design, with 3-panel structure Nano-fibre filters Moisture-resistant filter retains effectiveness in humid environments More breathable compared to traditional meltblown filters Meets Australian Standard AS/NZS 1716 Medical Device Class 1 Made in Australia ARTG listed - 335982 Code: AMD P2 N4HL, AMD P2 N4HM, AMD P2 N4HS
$83.50 - $129.00
-


Ultra Health Hammer Anti-Fog Safety Glasses - Clear
Versatile medium-impact eye protection with UV shield The Ultra Health ARC VISION Hammer Anti-Fog Safety Glasses is perfect for everyday PPE for eyes in various industrial settings. Meeting the highest safety standards, these lightweight safety glasses are designed with a close fit that provides an additional shield against particles and splashes. The anti-fog treatment ensures crystal-clear vision even in challenging conditions, making these glasses an ideal choice for anyone seeking reliable eye protection while the scratch-resistant coating adds an extra layer of durability for long-lasting use. The non-reflective lenses and UV protection make them versatile, suitable for both indoor and outdoor tasks. Key Features: Lightweight design for comfortable wear Hard-coated polycarbonate non-reflective lens Anti-fog treated Scratch-resistant for long-lasting clarity Medium impact resistance for added protection UV protection treated Close fit design for extra protection against particles and splashes Australian standard safety glasses Certified to AS/NZS 1337:2010 Applications: Best safety glasses for protection against particles & splashing materials. Ideal for general work, lab, medical, construction, chemistry environments and more. Product code: 900070
$2.30 - $286.00
-


SAN-AIR HVAC-R Anti-Microbial Surface Sealer Concentrate
HVAC-R Surface Sealer for Ductwork Sealing & Contamination Control Product code: 630-145, 630-146 The SAN-AIR HVAC-R Anti-Microbial Surface Sealer Concentrate is a powerful HVAC duct sealant designed to protect ductwork and air systems from microbial contamination. Formulated for duct sealing, this solution prevents mould, bacteria, and biofilm buildup, improving indoor air quality and extending the life of HVAC systems. Its advanced formula forms a protective barrier inside air ducts, acting as an air vent sealer to reduce leaks and maintain system efficiency. Safe, non-toxic, and easy to apply, this HVAC-R surface sealer ensures cleaner air and a healthier environment. Key Features: Effective duct sealing & protection Long-lasting HVAC duct sealant Enhances indoor air quality Safe & non-toxic formula Easy application for ductwork sealing Improves HVAC system efficiency Made in Australia with Australian ingredients Download Specification Sheet Download Safety Data Sheet (SDS)
$499.00 - $980.00
-


SAN-AIR Condensate Drain Sanitiser 250g
Target mould and bacteria at the source for a healthier, more efficient air conditioning system The SAN-AIR Condensate Drain Sanitiser is a powerful, all-natural solution specially designed to clean and maintain your air conditioning system’s drain lines. Ideal for cleaning air conditioner drains and preventing blockages, this easy-to-use product effectively removes biofilm, mould, and microbial build-up that can cause unpleasant odours, reduce system efficiency, or even lead to water damage. Formulated using SAN-AIR’s patented natural technology, this aircon drain cleaner works by breaking down organic contaminants within the AC condensate line—helping to maintain hygiene and airflow performance. It’s the perfect AC drain line cleaner for homes, commercial buildings, or anywhere indoor air quality is a priority. Key Benefits: Fast acting Cost effective and long lasting Simple to apply—just pour directly into the drain pan or pipe 100% natural and non-corrosive Free from harsh chemicals Safe for use in residential, commercial, and healthcare environments Animal and pet friendly Made in Australia with environmentally conscious ingredients Applications: Drain Trays Floor Drains Air Conditioning Systems & Air Handlers Refrigerators & Cold Storage Rooms Product code: 630-099 Download Safety Data Sheet (SDS)
$49.50 - $742.50
-


Duracell Ultra Alkaline D Batteries - Pack of 2
Reliable D type batteries delivering consistent, long-lasting performance Duracell Ultra D Batteries are engineered for high-drain devices that demand dependable, long-lasting power. Key Features: Long-lasting power for high-drain devices Duralock technology Leak-resistant Long shelf-life Ideal for everyday use High capacity Reliable constant power output Built with advanced Duralock Power Preserve™ Technology, these size D batteries retain power for up to 10 years in ambient storage, making them the perfect backup energy source to keep at home, in the workshop, or on the go. Unlike lower-grade batteries, Duracell Ultra ensures fewer replacements and consistent energy output for your high-performance electronics. These D type batteries are designed with alkaline technology, providing a stable voltage output and excellent resistance to leakage. They’re ideal for a wide range of everyday and specialty devices—from torches and radios to shavers, electronic toys, and more. Whether you're powering a heavy-duty flashlight, a portable speaker, or motorised toys, these Duracell D batteries deliver exceptional performance where it matters most. Product code: 5011868
$11.00 - $528.00
-


AC 3V/1A Power Supply Adapter – Australian Plug
Reliable Power for Your Devices – Compact & Compatible Keep your low-voltage electronic devices powered safely and efficiently with this AC 3V/1A Power Supply Adapter featuring a standard Australian plug. Whether you're replacing a lost charger or setting up a new device, this AC adapter offers a stable power source with consistent 3V output and 1A current—ideal for compatible electronics, small appliances, DIY projects, and more. Designed specifically for Australian outlets, this power adapter eliminates the need for converters. It's lightweight and compact, making it a convenient plug adapter to keep at home, in the office, or your workshop. Key Features: 3V/1A output Suitable for a variety of low-power devices Compatible with standard Australian power outlets Lightweight & compact Designed for long-lasting use with minimal heat output Heads up! Buying this for one of our fan diffusers? This adapter is only compatible with the Fan Fresh white fan diffuser model available in this link. It will not work with the blue or grey air diffuser models.
$14.95 - $19.95
-


SAN-AIR Hygiene HVAC-R Coil & Machine Cleaner Concentrate
Effective Aircon Cleaning Solution for Improved Performance Keep your air conditioning system running efficiently with SAN-AIR Hygiene HVAC-R Coil & Machine Cleaner Concentrate. This powerful air conditioner cleaner effectively removes dust, dirt, and microbial buildup from coils and internal components, improving airflow and system performance. Ideal for aircon cleaning, it is non-toxic, biodegradable, and safe for use in residential, commercial, and industrial settings. Perfect for split system air conditioner cleaning and other air conditioning cleaning products, this AC cleaner enhances air quality and extends equipment lifespan. Key Features: Effectively removes dirt, dust, mould, and bacteria from AC coils and machinery for optimal performance. Biodegradable and non-toxic, making it safe for users and the environment. Reduces allergens and airborne contaminants for cleaner, healthier air circulation. Helps maintain efficiency and prevent breakdowns by keeping coils and components clean. Suitable for split systems, HVAC-R units, and various air conditioning systems. Can be diluted for cost-effective use while maintaining strong cleaning power. Simple application process with no harsh chemicals or strong odours. Product code: 630-030, 630-031 Download Safety Data Sheet (SDS) Download Product Data Sheet (PDS)
$65.70 - $620.52
-


Airogenix Mould & Bacteria / Yeast DIY Test Kit
Accurately Detect Mould, Bacteria and Yeast at Home The Airogenix Mould & Bacteria / Yeast DIY Test Kit offers a simple, reliable, and accurate way to detect microbiological contamination in your environment. Designed for both professional and household use, this DIY mould test kit enables you to monitor the presence of mould, yeast, and bacteria quickly — whether in your home, workplace, or industrial setting. Each dipslide mould test kit features a dual-sided paddle with specialised agar on each side: one for total bacterial count (Nutrient Agar with TTC dye) and the other for yeasts and moulds (Malt Extract Agar). When exposed to your sample, microbial colonies grow as visible red or brown spots, allowing for easy interpretation and assessment. Perfect for anyone wanting to test for mould in the home or ensure environmental hygiene in industrial, food, or water systems, this home mould test kit delivers dependable results without the need for complex lab equipment. Key Features: Dual Detection Capability: Each dipslide tests for both total bacteria count, yeasts and moulds using high-quality nutrient and malt extract agar. Flexible, Strong Paddle: Designed for safe and consistent sampling across flat or irregular surfaces. Easy-to-Use Design: Simply dip, swab, or press the slide against the test area, then incubate to view results. Recessed Handle for Hygiene: Keeps hands dry and prevents contamination during testing. Clear Result Interpretation: Red colonies for bacteria and brown for yeasts/moulds for quick visual reference. Reliable & Long Shelf Life: 9-month shelf life from production with storage at room temperature (8°C–15°C). Product code: DS110220 Shop San-Air mould removal products if mould is active. Made in United Kingdom
$38.00 - $130.00
-

SAN-AIR™ Mould Remover Bundle with Nano Atomizer
Get long-lasting protection against mould The SAN-AIR™ Mould Remover Bundle with Nano Atomizer gives you everything you need to remove mould effectively and help prevent it from returning. The bundle includes: 1 × SAN-AIR™ Portable Nano Atomizer 1 × SAN-AIR™ Surface Mould Remover 1 × SAN-AIR™ Mould Gone The Mould Remover Spray is made from 100% natural actives that are powerful enough to eliminate 99% of airborne bacteria, mould, fungus, and spores, yet still safe for use around kids, pets, pregnant women, and plants — giving you peace of mind for your entire family. The Nano Atomizer helps you apply the Mould Remover Spray evenly, allowing the fine mist to reach difficult areas and improving overall effectiveness. The Mould Gone Gel continues working in the background after cleaning, helping prevent mould regrowth for up to 3 months. This means less frequent cleaning and reduced reapplication, saving you time and effort in the long run. With the SAN-AIR™ Mould Remover Bundle with Nano Atomizer, you can clean, treat, and protect your space naturally and effectively. Watch how to use the diffuser with SAN-AIR reactive gels HERE
$109.95
How do I use SAN-AIR
For information on how to use SAN-AIR products and what you need for your environment, visit our resource page here
Can mould make you sick?
Mould produces substances called mycotoxins, and exposure to these mycotoxins can lead to various health issues. Common symptoms of mould exposure include respiratory problems, nasal congestion, throat irritation, coughing, wheezing, skin irritation, and eye irritation. Individuals with allergies or respiratory conditions may be more susceptible to the adverse effects of mould.
In some cases, prolonged exposure to mould can contribute to more severe health issues, especially in individuals with compromised immune systems.
Can mould spread?
Mould spreads through airborne spores, transported by air currents, people, animals, or objects. Settlement occurs in conducive environments with moisture, warmth, and organic materials.
Do you know that your air conditioner can contribute to the spread of mould in your home?
This is why it is also important to regularly inspect and maintain your air conditioner is crucial to prevent moisture buildup, a significant factor in curbing mould proliferation.
What products should I use in my Air Conditioning unit?
You can use the SAN-AIR V3R Air Conditioning or Split System Gels. Read this guide for more information or watch this video
Where can I use the mould remover products?
You can use the SAN-AIR Mould Removal products anywhere where you see mould growing, this can include on:
- Clothes
- Furniture
- Bathrooms
- Walls
- Window Sills
- Caravans or storage areas
- Boats
- Air conditioning units
- Showers
- Curtains or blinds
- Outdoor furniture
- Car interiors
And so much more .... (please note we do recommend starting with a test patch on fabrics or furniture)
Does the mould removal gel have strong odour?
SAN-AIR™ Mould Gone may have a mild odour; however, it is not overwhelmingly strong and should not be too bothersome to the senses. The slight scent present is a natural characteristic of the product from the natural ingredients.
Can I send my SAN-AIR Test Kit to a lab for more specific results, and where can I send it?
Yes, you can! If you'd like a lab to perform a more detailed analysis on your SAN-AIR Bacteria & Mould Test Kit, we suggest contacting one of the following labs in Australia:
Please note that you'll need to provide your own incubator (thermos box) to keep the sample safe during transport. Aussie Pharma Direct currently does not sell these, so it will need to be sourced separately.
Which one do I need; Surface Mould Remover Spray or LD Concentrate?
Below is a brief summary on the differences between San-Air Surface Mould Remover and the LD Concentrate. Both products share similar core benefits such as high efficacy against mould and bacteria, safety features, and eco-friendly formulations. The main differences lie in their specific use cases, application methods, and the need for dilution in the LD Concentrate, making it more suitable for larger and heavily soiled areas, while the Surface Mould Remover is designed for direct, ready-to-use applications on various surfaces.
For full details see: SAN-AIR PDS Surface Mould Remover; SAN-AIR PDS LD Concentrate
San-AIr - Differences between Surface mould remover & LD Concentrate - Short Table by APDGeneral FAQs
How do the natural actives in SAN-AIR™ products compare to traditional chemical mould removal solutions?
Traditional chemical solutions, including bleach, can be neutralised by mould's exoenzymes, allowing it to thrive. Mould's adaptability to various conditions and nutrients poses a challenge for chemical approaches. For effective mould eradication, plant-based or enzyme-based solutions prove more potent. SAN-AIR™ utilises a unique formulation with natural substances that disrupt mould growth, offering a sustainable and effective solution to prevent and eliminate mould
Is it necessary to use the AMD P2 respirator during the mould removal process?
Yes, using the AMD P2 respirator is crucial during the mould removal process. Inhaling mould spores, especially during cleaning, poses potential health risks. The AMD P2 respirator is designed to filter out 99.66% of airborne particles, providing essential protection and ensuring a safer environment during mould removal activities.
Can the SAN-AIR™ Mould Removal products effectively eliminate stubborn mould stains?
Yes. The SAN-AIR™ Surface Mould Remover is specifically formulated to tackle stubborn mould stains. To use, simply spray the product on the targeted surfaces, allowing it to sit for approximately 10 minutes before wiping or scrubbing with clean cloths or a sponge. For optimal results, change the cloth and sponge frequently during use. Once the cleaning process is complete, lightly spray the product on the surface and let it air dry.
Are there any specific surfaces or materials where the SAN-AIR™ products should not be applied?
SAN-AIR™ Mould Removal products are designed for versatility, and you can confidently use them on any surfaces or materials. Whether it's walls, ceilings, fabrics, or hard surfaces, our products are formulated to effectively address mould-related challenges across a wide range of materials.
How often should I use SAN-AIR™ products to prevent mould growth in my home?
Once you've completed the initial mould removal during cleaning, consider using SAN-AIR™ Mould Gone Reactive Gel for ongoing prevention. Place the gel in areas prone to moisture and humidity to create a protective barrier against mould growth. This proactive approach provides 24/7 protection for up to 3 months. However, it's essential to note that regular monitoring, especially during the wet season, is advisable. Despite the extended protection, best practices involve keeping a vigilant eye for any signs of mould growth and taking prompt action if observed.
Read Reviews about SAN-AIR
Related Articles About Mould & SAN-AIR Solutions
Learn about SAN-AIR’s natural mould-fighting properties and tips for keeping mould at bay.